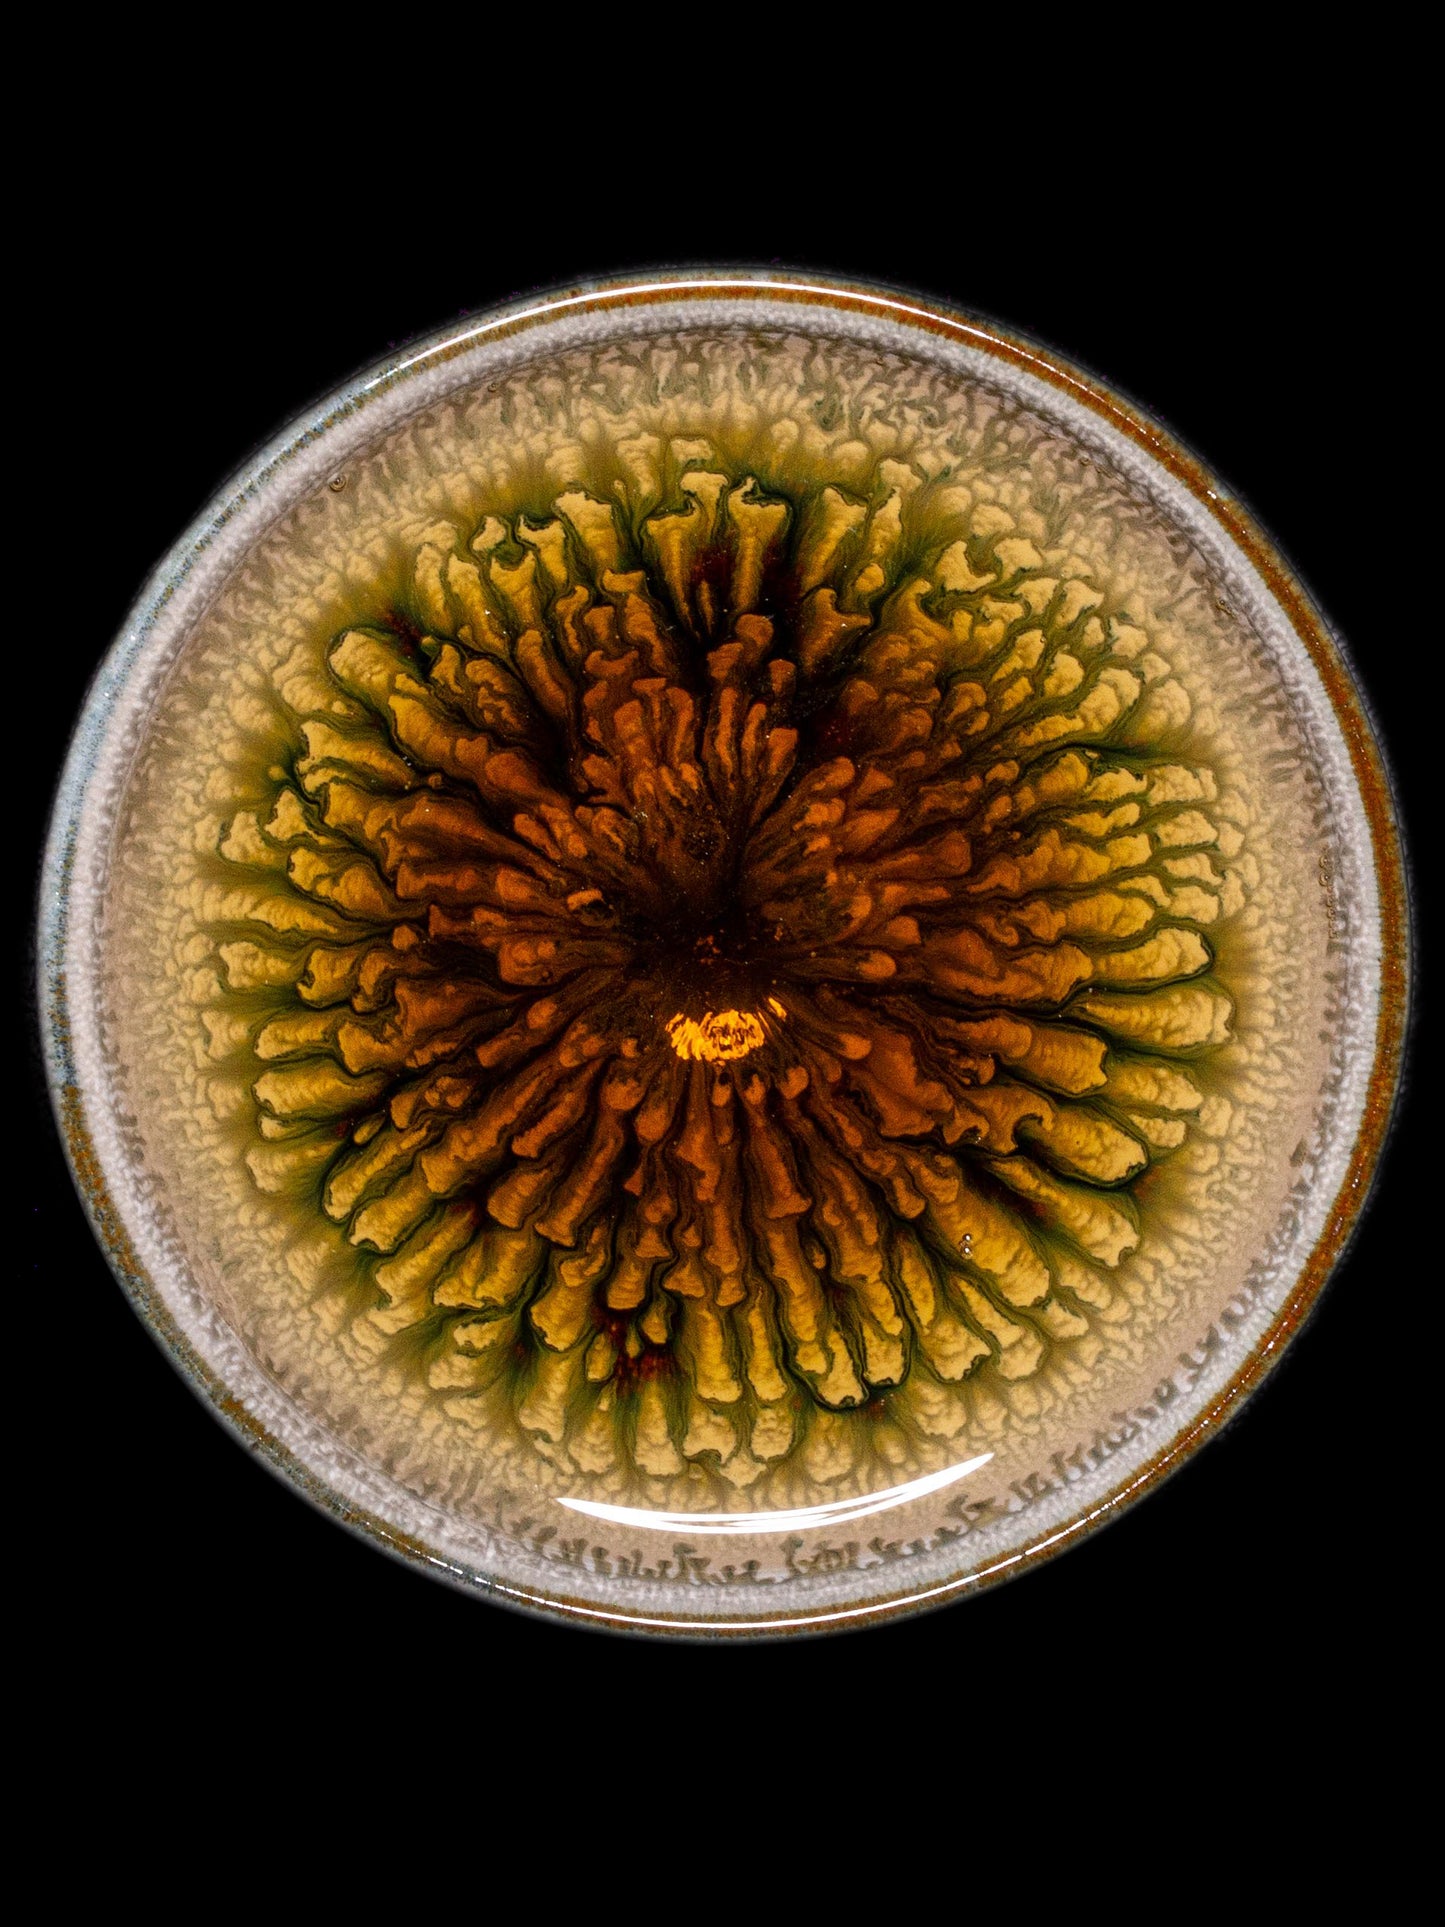
White Peony (9.2cm)

1
/
of
10
Porcelain.artistry
White Peony (9.2cm)
White Peony (9.2cm)
Regular price
$119.00 USD
Regular price
Sale price
$119.00 USD
Quantity
Couldn't load pickup availability